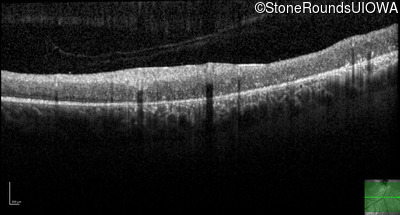
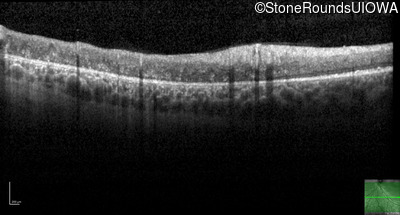
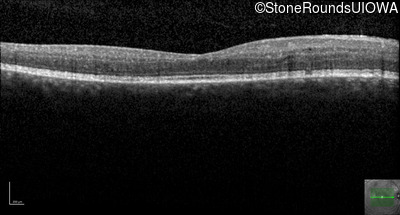
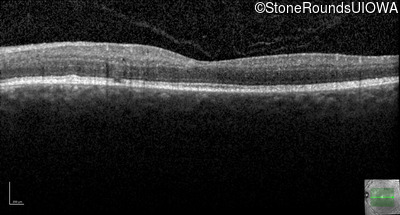

Case
SR1777
Student Mode
Enhanced S-Cone Syndrome (IA2fiv)
Male
Male
Hidden
SR1777
Student Mode
Enhanced S-Cone Syndrome (IA2fiv)
Male
Male
History
This 45 year old man has had poor night vision since at least age 2 years.
| Refraction OD: | +0.25 +0.50 x 30 |
|---|---|
| Refraction OS: | Plano +1.00 x 155 |
Teaching Points
The clinical features supporting the diagnosis of the enhanced S-cone syndrome (ESCS) in this patient include: stable night blindness since at least the second year of life, normally sighted parents, nummular pigment in the mid-periphery of the fundus that stops abruptly at the temporal arcades and disorganization of the retinal layers (seen on OCT) anterior to the temporal arcades.
| Age at visit: 45 years |
Diagnosis & molecular findings
| Disease | Gene | Allele 1 variant(s) | Allele 2 variant(s) | Inheritance mode |
|---|---|---|---|---|
| Enhanced S-Cone Syndrome | NR2E3 | IVS1-2 A>C | Arg311Gln CGG>CAG | AR |
Disease:
Gene:
Allele 1:
IVS1-2 A>C
Allele 2:
Arg311Gln CGG>CAG
Inheritance:
AR